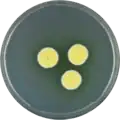
Aspergillus campestris growing on CYA plate

| Aspergillus campestris | |
|---|---|
| Scientific classification | |
| Domain: | Eukaryota |
| Kingdom: | Fungi |
| Division: | Ascomycota |
| Class: | Eurotiomycetes |
| Order: | Eurotiales |
| Family: | Aspergillaceae |
| Genus: | Aspergillus |
| Species: | A. chevalieri |
| Binomial name | |
| Aspergillus chevalieri M. Chr. (1982)[1] | |
Aspergillus campestris is a species of fungus in the genus Aspergillus. The species was first described in 1982.[1] It is from the Candidi section.[2] The fungi in the Candidi section are known for their white spores.[2] It has been shown to produce a high number of secondary metabolites.[2]
The genome of A. campestris was sequenced as a part of the Aspergillus whole-genome sequencing project - a project dedicated to performing whole-genome sequencing of all members of the genus Aspergillus.[3][4] The genome assembly size was 28.26 Mbp.[3][4]
Growth and morphology
A. campestris has been cultivated on both Czapek yeast extract agar (CYA) plates and Malt Extract Agar Oxoid® (MEAOX) plates. The growth morphology of the colonies can be seen in the pictures below.
Aspergillus campestris growing on CYA plate
Aspergillus campestris growing on CYA plate Aspergillus campestris growing on MEAOX plate
Aspergillus campestris growing on MEAOX plate
References
- 1 2 Christensen, M. 1982. The Aspergillus ochraceus group: two new species from western soils and a synoptic key. Mycologia. 74(2):210-225
- 1 2 3 Rahbæk, Lisa; Frisvad, Jens; Christophersen, Carsten (November 1999). "An amendment of Aspergillus section Candidi based on chemotaxonomical evidence". Phytochemistry. 53 (5): 581–586. doi:10.1016/S0031-9422(99)00596-8. PMID 10724184.
- 1 2 Kjaerbolling I, Vesth TC, Frisvad JC, Nybo JL, Theobald S, Kuo A, Bowyer P, Matsuda Y, Mondo S, Lyhne EK, Kogle ME, Clum A, Lipzen A, Salamov A, Ngan CY, Daum C, Chiniquy J, Barry K, LaButti K, Haridas S, Simmons BA, Magnuson JK, Mortensen UH, Larsen TO, Grigoriev IV, Baker SE, Andersen MR Linking secondary metabolites to gene clusters through genome sequencing of six diverse Aspergillus species. Proc Natl Acad Sci U S A. 2018 Jan 23;115(4):E753-E761. doi: 10.1073/pnas.1715954115. Epub 2018 Jan 9.
- 1 2 "Home - Aspergillus campestris IBT 28561 v1.0". genome.jgi.doe.gov.
This article is issued from Wikipedia. The text is licensed under Creative Commons - Attribution - Sharealike. Additional terms may apply for the media files.